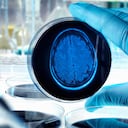
El cerebro también requiere de ciertos cuidados para mantenerse sano.

Una sana apariencia de las uñas es reflejo de la buena salud del organismo, por lo que para mantenerlas fuertes es importante cuidar del cuerpo y procurar que este reciba todos los nutrientes que necesita.
Así como el cabello, las uñas se componen de una proteína llamada queratina, la cual se encarga de darles firmeza. Por ello, cuando se presenta una deficiencia de este elemento en el organismo, las uñas tienden a volverse quebradizas y perder su resistencia.

Las vitaminas son uno de los seis nutrientes esenciales para el ser humano, ya que algunas de ellas favorecen la producción de proteínas en el cuerpo, las cuales ayudan al correcto funcionamiento del organismo. Por ello, se recomienda una ingesta adecuada de vitaminas para mejorar el aspecto y la salud de las uñas. ¿Cuáles son las más recomendadas?
Recomendaciones para el cuidado de las uñas
De acuerdo con el portal de salud unCOMO, hay seis vitaminas que favorecen la buena salud de las uñas y permiten que recuperen su fuerza. Estas son la biotina o vitamina B7, el ácido fólico o vitamina B9, la cobalamina o vitamina B12, la vitamina A, la vitamina C o ácido ascórbico y la vitamina E.
Primero, la biotina es una coenzima que hace parte del complejo de vitamina B. Esta se encarga de diversos procesos en el cuerpo, como el metabolismo de las proteínas y otros nutrientes. Según explica el mencionado portal, este nutriente también cumple la función de conservar las células musculares y aporta en la buena salud de las uñas, el cabello y la piel. Se encuentra generalmente en alimentos como la yema del huevo, levadura de cerveza, avena y en otras presentaciones como suplementos vitamínicos.
De esa misma familia, la vitamina B9 o ácido fólico es fundamental para el crecimiento y conservación de varias de las partes del cuerpo, gracias a sus propiedades regeneradoras. De acuerdo con unCOMO, este nutriente es esencial para la producción de células y la estructura de estas, así como de su regeneración y crecimiento, por lo que un déficit de vitamina B9 puede provocar uñas quebradizas. Consumir alimentos ricos en este componente como las espinacas, la remolacha, las lentejas y los garbanzos pueden ayudar a mejorar la apariencia de las uñas.
Otro de los miembros del complejo B es la cobalamina, o vitamina B12, la cual se caracteriza por favorecer la producción de queratina. La ingesta insuficiente de este nutriente puede alterar el correcto funcionamiento del cuerpo, como disminuir la producción de queratina, componente principal de las uñas.
La vitamina A tiene propiedades claves para recuperar los tejidos del organismo, por eso es importante una ingesta adecuada de este nutriente, para favorecer el crecimiento de las uñas y su apariencia sana. Asimismo, como explica el referenciado portal, la vitamina A posee una acción antioxidante, la cual protege a las uñas de factores externos que pueden dañarlas.

Otro de los nutrientes reconocido por sus propiedades antioxidantes es la vitamina E, la cual es esencial para mejorar la resistencia de las uñas ante factores externos que puedan quebrarlas, además ayudan a aliviar otras molestias que puedan afectarlas debido a sus propiedades reparadoras y cicatrizantes.
La vitamina C, o ácido ascórbico, tiene diversas propiedades que son beneficiosas para la salud del cuerpo en general y, por tanto, de las uñas. Este nutriente contribuye a una mejor absorción del hierro, proteger las uñas de los radicales libres que afectan a las células y fortaleciendo las defensas ante enfermedades que puedan cambiar la apariencia de las uñas.

Signos de alerta de otras afecciones
En ocasiones, las uñas pueden alertar acerca de otras enfermedades de base, las cuales pueden ser la causa de su apariencia débil y quebradiza. En ese sentido, Mayo Clinic recomienda asistir al médico si la persona observa alguna de estas molestias:
- Cambios de color en la uña, como decoloración de toda la uña o una línea oscura debajo de ella.
- Cambios en la forma de la uña, como uñas curvadas.
- Adelgazamiento o engrosamiento de las uñas.
- Separación de la uña de la piel que la rodea.
- Sangrado alrededor de las uñas.
- Hinchazón o dolor alrededor de las uñas.
- Falta de crecimiento de las uñas.
